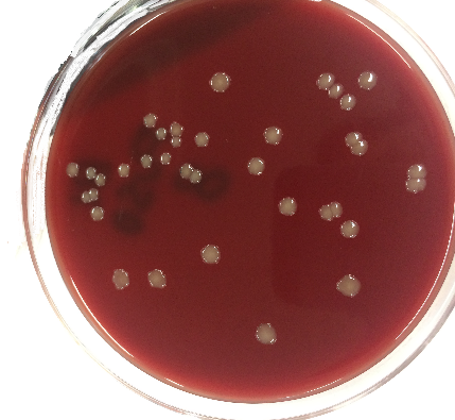

本学の獣医学部は、約140年の歴史を有する国内最古の私立獣医学校を起源とする獣医学科と、日本で初めて創設された獣医保健看護学科からなります。
この間、多くの卒業生を社会に輩出し、臨床獣医師はもちろん、公務員獣医師、研究者、動物看護師など、多岐にわたる分野で本学出身の先輩たちは活躍しています。
獣医学は動物の生命を守るばかりでなく、食の安全、安心を守る重要な社会的役割を担っています。
また、近年の動物愛護法で謳われているように、動物の生命を尊び、それを保護する活動を獣医師、動物看護師は実践しています。
本学獣医学科は、過去に魚病学(水族医学)研究室や野生動物学研究室を、他の大学より早く立ち上げ、獣医学の分野で常に先駆的な革新を行なってきました。
さらに、シェルターメディスン教育として、災害獣医学、法獣医学、集団獣医学を今後地域とともに展開していく予定です。一方、獣医保健看護学科は、愛玩動物看護師の国家資格化に伴うカリキュラム変更も済み、
今後、愛玩動物看護学の発展を牽引していく立場にあります。
獣医療は医療技術の進歩により、愛玩動物の寿命が年々延びていることから、さらに複雑な疾患を対象にしなければならず、獣医師、動物看護師がチーム一丸となって適切な治療を行う必要性があります。
このため、動物医療センターには最新の放射線治療装置をはじめとする高度医療機器が設置され、学生実習をサポートできる専任の獣医師、動物看護師の指導の下、最先端の知識や技術を習得できるようになっています。
本学獣医学科および獣医保健看護学科では、付属動物医療センターで行う臨床実習を通じて、臨床経験だけでなく、将来、科学的根拠に基づいた治療を行うことのできる動物の医療人を育てます。